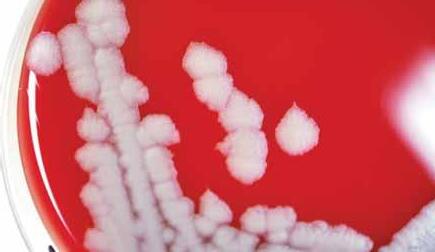

11 minute read
The righT sorT of help
sT uden T s provide ex T ra hands in emergencies
In 1996, a disgruntled laboratory worker intentionally sickened several people at St. Paul Medical Center in Dallas. Twelve coworkers became ill after eating baked goods infected with a rare strain of Shigella, which causes dysentery.
Shauna Mettee 09 MSN/MPH, then an Emerging Infectious Disease Laboratory Fellow at the CDC, accompanied the agency’s investigative team to the scene. During that time, she gained experience and formed relationships that would later benefit her and other RSPH students.
More than 10 years later, she joined Rollins’ Student Outbreak and Response Team (SORT), a volunteer group trained to assist with local outbreak investigations and emergency preparedness. Formed in 2002, SORT was the brainchild of Sara Forsting 01MSPH, then an epidemiologist with the DeKalb County Board of Health Center for Public Preparedness. Rollins Professor Ruth Berkelman supported the idea. The program took off as students took the lead to improve community health in partnership with local and state experts.
In 2008, Mettee began thinking about how to broaden SORT’s scope. With Berkelman’s encouragement, Mettee and SORT co-leader Amy Williams 09MPH reached out to the CDC. Ian Williams, chief of the Outbreak Response and Prevention Branch, advocated for the collaboration, which included obtaining CDC badges for the entire team—an essential asset when SORT’s 40 members are asked to work at the agency during outbreak responses.

To date, 200 students have participated in SORT. All are trained in disaster preparedness through the National Incident Management Command System and are certified as Red con T inued on page 13
Health Preparedness and Research
(CPHPR). “One way we are conducting research is by examining a number of recent disasters, finding ‘lessons learned,’ and sharing them with our partners in public health and the community.”
Before leading the center, Berkelman served as a senior public health official at the cdc and in 2000 became a consultant to the Nuclear Threat Initiative in the area of biologic weapons and disease surveillance, while also teaching a course on emerging infectious diseases at Rollins. Following 9/11, Dean James Curran recruited her to lead the CPHPR, established with a gift from the O. Wayne Rollins Foundation and supported with funding from the cdc, nih, and other federal agencies.
Research and collaborations established by the CPHPR laid the groundwork for receiving a multi-year cdc grant to establish the Emory Preparedness and Emergency Response Research Center (perrc), one of seven such centers funded in 2008 across the country. These centers were the result of the first federal funding to schools of public health to address the need for an evidence base for public health preparedness programs.
“We’re still in a nascent stage of preparedness and disaster research,” says Berkelman, who directs the Emory perrc.“We need to know how people respond. If an event happens in a community, what will make that community more resilient? How can they rely on their public health department, and how can we make that public health department more potent working in collaboration with others?”
Ellen Whitney 01mph, director of research projects for the CPHPR and associate director of the Emory PERRC, concurs. “We are building new areas of research that will supplement and improve the public health response,” says Whitney, a former cdc epidemiologist who assisted with the 2001 anthrax investigation.


c losing T he immunizaT ion loop
Four interdisciplinary perrc projects are building that science. A project led by vaccine safety expert Saad Omer has yielded new best practices and policies, based on the Haemophilus influenzae Type b (Hib) vaccine shortages from 2007 to 2009 and the response to pandemic H1N1 influenza in 2009. To gather evidence, Omer’s team surveyed two groups—immunization program managers (IPM s) and health care providers with the goal of examining the U.S. immunization system and its capacity for effectively distributing vaccines and other countermeasures during an emergency.
Data collected from IPM s on the Hib vaccine shortage suggest that improving vaccine transfer between jurisdictions and using immunization information systems to track compliance with shortage recommendations by providers could help the U.S. immunization system respond more effectively to future vaccine shortages and emergencies.
During a crisis, state health departments turn to their IPM s and emergency preparedness (EP) program managers to respond. In 2010, Omer’s team studied how immunization programs and practices managed the response to H1N1 in 2009.
Researchers considered several factors: vaccine campaign management, collaborations between state immunization and emergency preparedness programs, the use of incident command and emergency operations centers, the use of immunization information systems, and communication with health providers. Based on the results, the Association of Immunization Managers developed new national recommendations for working more closely with EP program managers to improve their response.

In Washington state, a survey of health providers showed that pharmacies could play a stronger role during public health emergencies by participating in disaster training, enhancing surge capacity, and improving communication and collaborations in public health.
“The pharmacies stood out as being a big provider in terms of their reach into communities,” says project coordinator Katy Seib 10MPH. “They indicated a desire for more outreach from their local health departments.”
During a vaccine shortage or crisis, providers depend on local and state health departments for
T he righ T sor T of help (con T inued)
Cross disaster volunteers. Students often take elective courses at Rollins, such as Public Health Preparedness and Bioterrorism, co-taught by Berkelman and global health Professor Phil Brachman (who investigated inhalational anthrax during the 1950s), and Emerging Infectious Diseases, co-taught by Berkelman and Ali S. Khan 00MPH. FBI instructors provide bioterrorism training, and Khan leads training in the CDC’s Emergency Operations Center (EOC).
Last year, SORT members helped staff the EOC during outbreak investigations of cholera in Haiti and cases of Salmonella Montevideo traced to Italian meat spices. Locally, they assisted DeKalb County with a flu immunization clinic and a MARTA disaster drill. Students also attended a national summit on public health preparedness and sponsored activities at Rollins, including a tour of Emory’s mock BSL-4 laboratory. Daniel Brencic and Carrie McNeil, current co-presidents of SORT, plan to broaden its relationships further.
Students carry their SORT experiences with them after graduation. Heidi Moline 10MPH, an associate analyst with the Union of Concerned Scientists in Washington, D.C., leads a project looking at how science is maintained and used in decision-making during disasters. At the CDC, Williams helped create a toolkit that U.S. health departments use to assess the needs of reproductive-age women affected by disasters. Mettee served two years as a CDC Epidemic Intelligence Service officer and is now a CDC Preventive Medicine Fellow assigned to work with three local county health departments.
Her assignment, she says, “will be the perfect synergy of my experience with SORT—combining the federal and local county public health perspective and developing and applying more leadership skills.”—Pam information. As Omer’s team learned, providers prefer using email, phone, and fax instead of Twitter and text messaging for communication. Early findings regarding communication were quickly disseminated to Washington’s local health departments, which used this information in allocating their increasingly scarce resources. Identifying such factors streamlines the public health response. a safe T y ne T for nursing homes When a disaster occurs, what happens to patients who are confined to nursing homes or depend on a home health provider? David Howard, a PERRC project leader and associate professor of health policy and management, is looking at ways to improve disaster planning for both types of providers.
“We’re learning valuable lessons that will raise the quality of evidence to influence policy at the national level and practice at the local level,” says Omer.


“There’s a great deal of attention paid to hospitals in preparedness,” says Howard. “This is a chance to focus on a segment of the provider community that has received little attention previously.”
In San Diego, nursing homes have banded together to share resources and information during a disaster in order to know who has supplies and available beds.

“One of the real strengths of the model is that preparedness planners meet before a disaster occurs and build up a community of informal ties they can draw on when disaster strikes,” says Howard. “We think this might be a good model for other jurisdictions to follow because it doesn’t tax government

Howard’s team has surveyed 296 nursing homes in California, Florida, and Georgia—all disaster-prone states— about their preparedness planning and capabilities. In coastal Georgia, many nursing homes rely on the same transportation providers for evacuation. In the event of a widespread disaster, bus and ambulance services would be overtaxed. And evacuating patients to a local hospital would be impossible because hospitals frequently discharge patients, often to nursing homes, in order to prepare for a surge.
“Doing a better job of system-wide planning is an important step going forward,” says Howard.
c ommanding T he si T uaT ion
In 2009, San Diego became ground zero for H1N1 in the United States. The cases spread from neighboring Mexico, where H1N1 was first detected. San Diego County’s response to the potential pandemic makes for a compelling case study in an Emory PERRC project led by Professor Kathy Miner 79mph, associate dean for applied public health.

“The H1N1 cases in San Diego marked the first time that public health assumed the lead emergency management role in a major event. We didn’t expect ‘ground zero’ in the U.S. to emerge in this way, and events didn’t unfold as anticipated,” says Miner, whose project looks at how incident command systems (icss) and emergency operations centers (eocs) are used in response to public health crises.

When the first case of H1N1 was identified, San Diego County public health officer Wilma Wooten stepped up to ensure coordination of activities in the county health department and with local hospitals and community providers. Wooten quickly established an eoc and organized county public health staff into an ics structure to meet the epidemiologic and disease control challenges.
Through case studies of H1N1 in San Diego and the 2009 ice storm in
Kentucky, Miner’s team is determining best practices in emergency planning and response. The investigators and the National Association of County and City Health Officials also are surveying state and local health departments to assess their use of icss and eocs.
As Miner explains, “We’re asking, ‘Did you use incident command? Did you open an emergency operations center? And as a result of that, have you started to think about using those systems for other responses?’ If their answer is ‘yes,’ that tells us that all of the training and preparation for one event may change the way they think about public health in the future.”
Miner has done her own share of preparedness training. From 2002 to 2010, she and Melissa Alperin 91mph led the Center for Public Health Preparedness (CPHP). The center excelled in using technology to train Georgia’s public health workforce via podcasts, CD-ROMS, web-based lectures, case studies, and other types of interactive training. Since its inception, CPHP distributed more than 57,000 copies of instructional materials to state and local public health workers in Georgia and the nation.
“What 9/11 and anthrax made clear is that public health is a primary response agency,” says Miner. “When that awareness occurred, there was an understanding that we have to prepare the public health workforce on how to assume this role.”
s chooled in disas T ers
In August 2005, the massive flooding caused by Hurricane Katrina forced thousands of Gulf Coast evacuees into Georgia. The Emory community rallied to cushion the evacuees’ arrival.
Emory’s response led Alexander
Isakov’s team to undertake a PERRC project exploring how colleges and universities can collaborate with disaster response agencies to increase and sustain community readiness and response.
“Traditionally, academic institutions are viewed as providing education and training for preparedness,” says Isakov, associate professor of
Sean Kaufman’s job takes him all over the country and around the world. Though it may sound glamorous, his job is vital to protecting researchers who work with deadly diseases in biosafety laboratories.

These high-tech, highly secure facilities handle viruses such as Ebola, Marburg Ebola, and Lassa fever. To minimize the risk of infection, researchers must master a multitude of safety measures and operating standards. There’s no better way to learn than through a hands-on training course in a mock biosafety level-4 (BSL-4) laboratory, says Kaufman. Here he wants trainees to make mistakes because there is little room for error in a real laboratory.
“You can learn about BSL emergencies from textbooks,” says Kaufman, “the same way you theoretically can learn emergency medicine and executive director of Emory’s Office of Critical Event Preparedness and Response. “But we believe they’re an often-overlooked community partner when response agencies are seeking to solve their disaster response needs.”
Those needs are vast and diverse: physical resources, such as shelter for evacuees; a solid public communications infrastructure; robust Internet technology resources; and subject matter expertise in public health, clinical and veterinary medicine, engineering, nursing, theological and pastoral care, and language translation.
Although an array of expertise is needed to effectively manage disaster response, all disasters have fundamental managerial elements that must be met. One is physical stability, a crucial aspect of disaster preparedness that is often overlooked.
“The fact that colleges and universities are part of the community and don’t typically relocate make them an ideal partner to public health agencies,” says Isakov.
Through PERRC, Isakov’s team looked at several FEMA-declared disasters to compare academic institutions that partnered with public health response agencies and those that did not during specific events.
The researchers found that having a shared response plan and shared field training helps schools and agencies work together more effectively. They also found that central coordination of academic institutions’ resources facilitates collaborative action with the public health response agency. For example, if a public health agency needs to distribute drugs for prophylaxis or post-exposure, schools could leverage their communications and to swim from a PowerPoint presentation. But the only real way to learn how to respond to BSL emergencies is by responding. Our program bridges the gap between knowing something and being able to do it quickly and with minimum risk.”
Kaufman designed the biosafety training course seven years ago after Ruth Berkelman, director of the Center for Public Health Preparedness and Research, received an NIH grant to create such a program. Berkelman tapped him for his expertise in human behavior and his affinity for working on infectious disease issues.
“Previously, training was behavior-based with little or no simulation training,” he says. “With hands-on training, we can move people from being novices, we can put them safely in settings of a laboratory emergency, and overall, we can begin to create experts.” logistics infrastructure to distribute the drugs to the community, reaching tens of thousands of people in some cases.
Because funding and preparation for disasters are cyclical, establishing relationships and cooperative plans before a disaster is essential, especially when funding is tight.
“Relationships are key,” says Berkelman. “Although we have different cultures, we’ve learned to understand each other and work together far better than 10 years ago.”
Her observation is timely, given that federal funding for preparedness research and training at schools of public health has been targeted for elimination in 2012 because of budget cuts. But the need to secure the scientific evidence for preparedness programs remains. As rsph Dean James Curran notes, “We must know what works in our communities to keep them safe.” if they try to walk across the room. “Students realize they are thinking at the speed of light, but they are moving at the speed of a turtle,” says Kaufman. b sl -4 laboraT ory paT hogens: ebola
In another scenario, he tells a participant to pretend to collapse on the floor. Other participants are inclined to rush over to the person, but what if a second person goes down? How do you move an unconscious co-worker? (Answer: with plastic trays.) How does one get out of the laboratory if the power has gone out? (Form a conga line to exit.)
( T op), marburg e bola, and lassa fever
Training scenarios are designed to induce frustration or panic. For example, learning how to move around in heavy protection gear is a feat in itself. Just squatting to pick up a dropped object is an exercise in strength and balance. Participants are tethered to air hoses and are yanked back
Since Kaufman designed the program, more than 2,000 participants have come through the doors of the mock laboratory on Emory’s Briarcliff Campus, including those from as far away as Pakistan, India, Singapore, and the Philippines. In the past 12 months, he has traveled to Jordan, Switzerland, India, Mexico, and Honduras, in addition to traveling domestically to the University of Florida, George Mason University, and UCLA.
For Kaufman, the best part of the job “is when participants learn to do something they thought impossible that will protect them in a laboratory emergency.”—Kay Torrance








